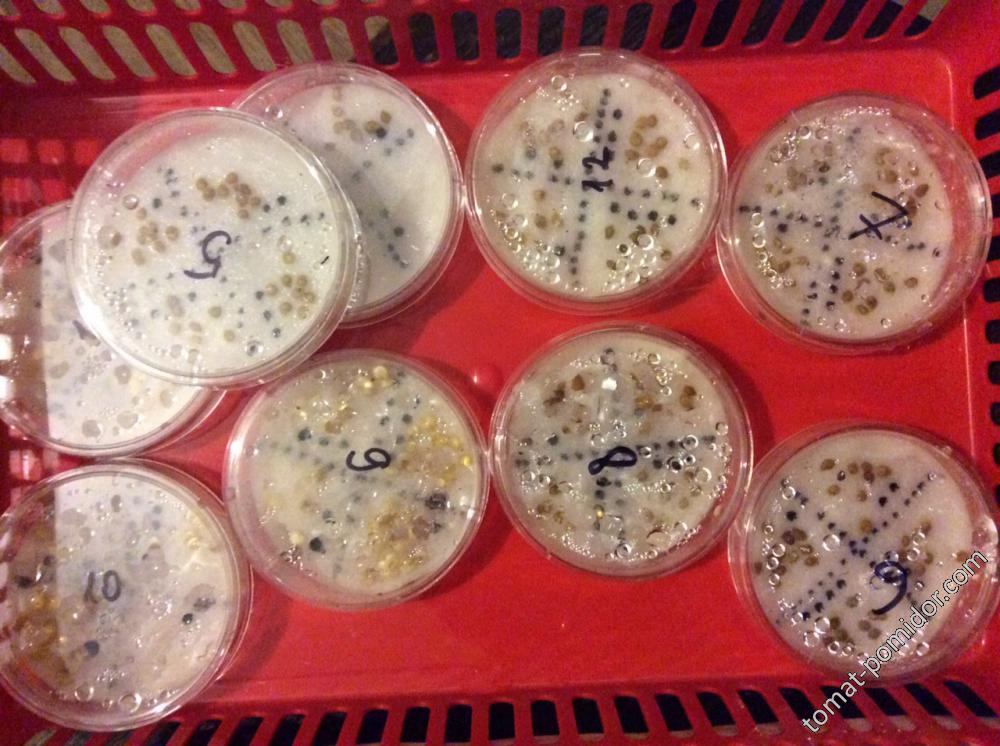

№ 0-9 А Б В Г Д Е Ж З И К Л М Н О П Р С Т У Ф Х Ц Ч Ш, Щ Э Ю Я a b c D e F G h i j k L m N o p Q R S t U V, W X, Y, Z
Новое в блогах
-
 Последняя запись Перцы Перцовичи.; обновлено
Последняя запись Перцы Перцовичи.; обновлено
Записей:62; комментариев:55
Цветы, томаты, бататы — Блог Apio
 Последняя запись Планы на сезон-2026; обновлено
Последняя запись Планы на сезон-2026; обновлено
Записей:47; комментариев:123
Шевячок и К — Блог Шевячок
.thumb.jpg.b54c4f367e3c64406a51771d92495e16.jpg) Последняя запись Лучок-2026; обновлено
Последняя запись Лучок-2026; обновлено
Записей:11; комментариев:109
Последняя запись Максимальная длина линии интерфейса i2c ?; обновлено
Записей:10; комментариев:2
×- Создать...

 Перейти к содержанию
Перейти к содержанию

.jpg.34e110f87702d1c26150330de0231efc.jpg)
